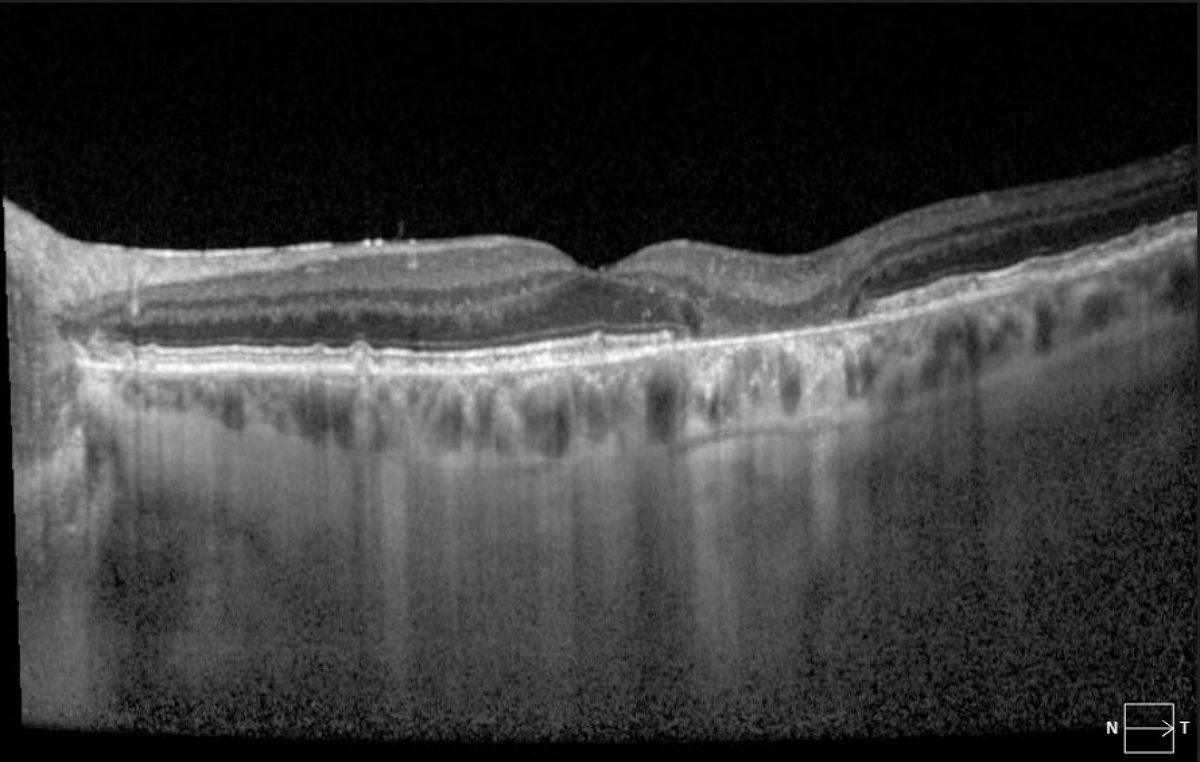
Extrafoveal geographic atrophy in an eye with dry AMD.
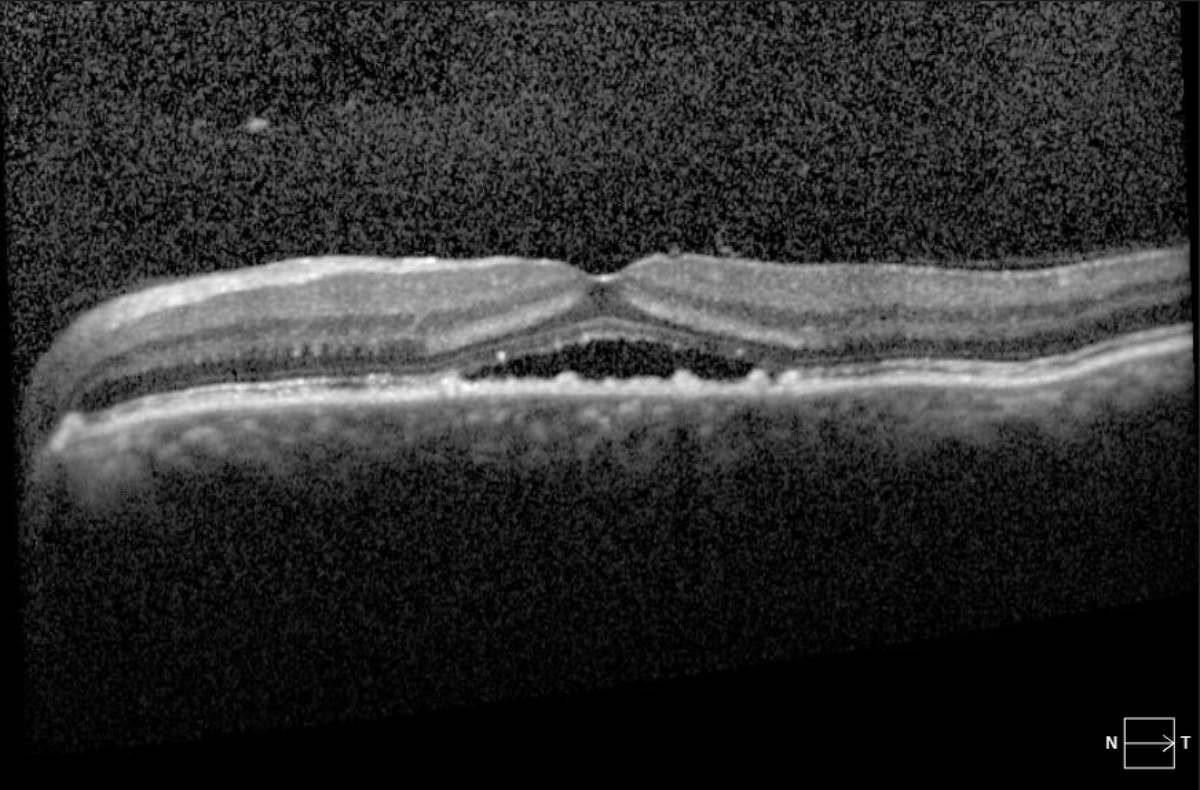
Chronic central serous retinopathy - starting, worsening, resolving - over 7 month period.
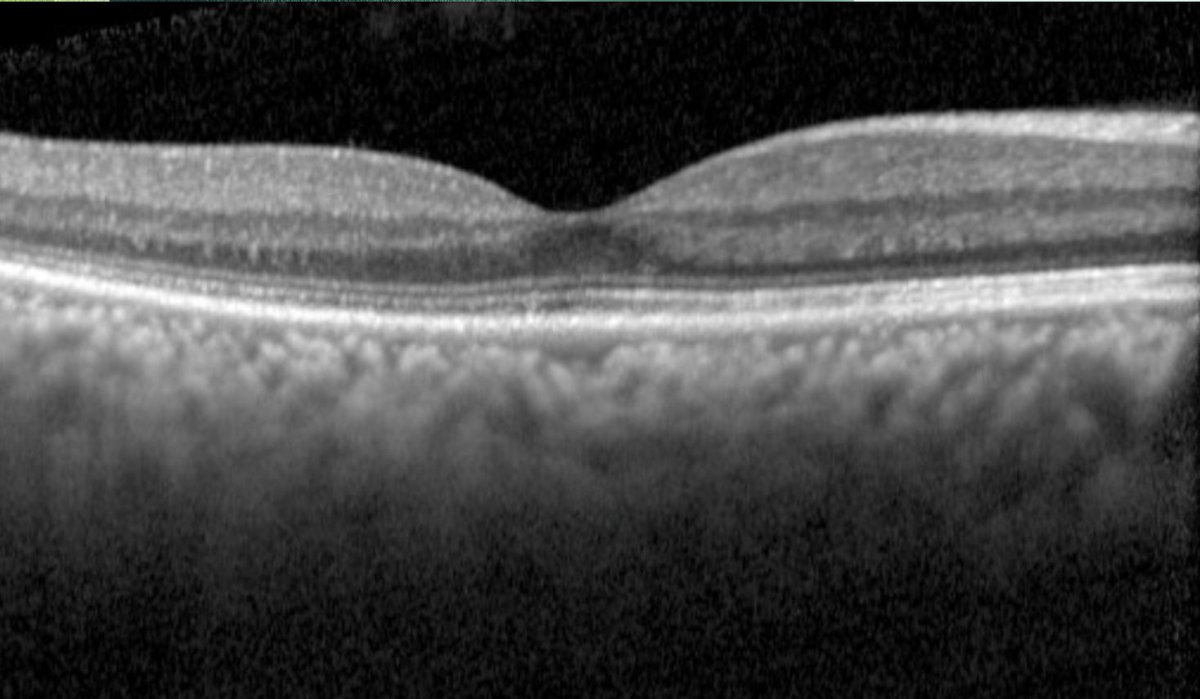
Central serous retinopathy. Note classic smokestack leakage temporally on fluorescein angiography. OCT demonstrates subretinal fluid (20/300) that resolved without treatment (20/40) in 2 months.
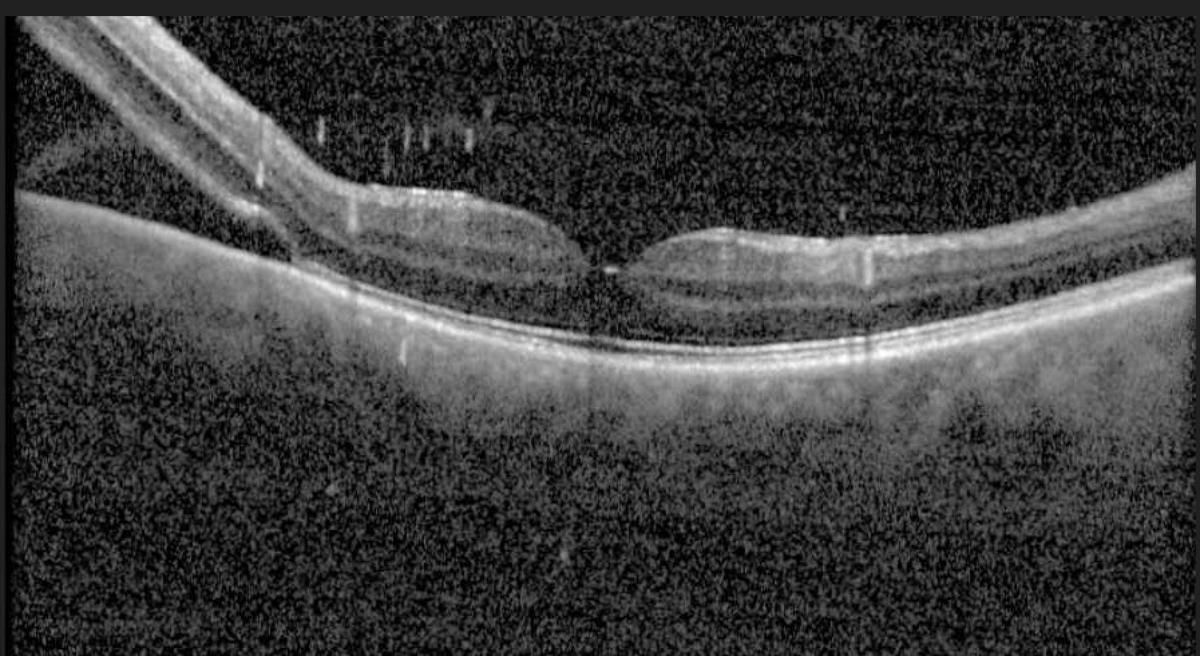
Fovea threatening retinal detachment.

TheRetinaSociety
@retinasociety
retinasociety.org Moderated by Sharon Fekrat MD FACS FASRS on behalf of the Website and Communications Committee.
ID: 1285938151433875456
http://www.retinasociety.org 22-07-2020 14:02:42
136 Tweet
622 Followers
5 Following